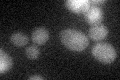
YOR100C
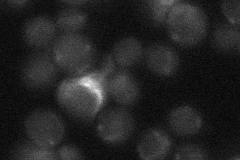
YOR100C
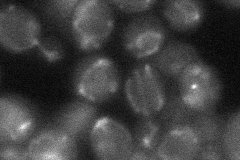
YOR100C

View description
Mitochondrial inner membrane carnitine transporter, required for carnitine-dependent transport of acetyl-CoA from peroxisomes to mitochondria during fatty acid beta-oxidation
Localization:
Intensity:
Fold change:
Significance:
-
C’ GFP library in SD
below threshold15.16 -
N' NOP1pr-GFP in SD

mitochondria89.169 -
N' TEF2pr-mCherry in SD

mitochondriaN/A -
N' NATIVEpr-GFP in SD
punctate18.3002 -
N' TEF2pr-VC and Cyto-VN in SD
mitochondria29.3632 -
C’ GFP library in SD+DTT

cytosol15.791.04No -
C’ GFP library in SD+H2O2

cytosol14.510.95No -
C’ GFP library in Starvation Media

cytosol17.751.17No -
C’ GFP library on the background of Pup2-DaMP

below threshold -
C’ GFP library on the background of CCT mutant

below threshold14.32260.944465No
